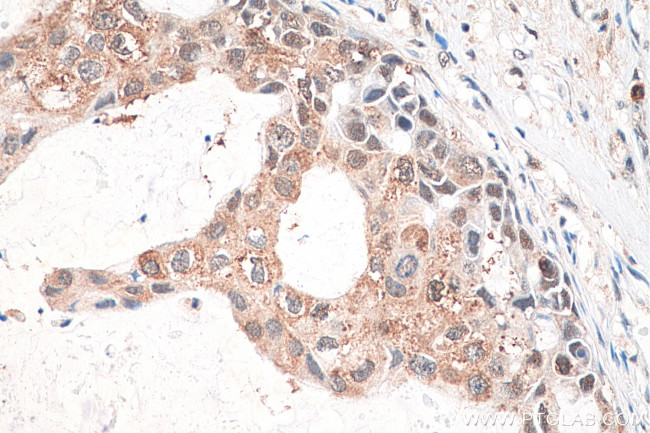
CXXC1 Antibody in Immunohistochemistry (Paraffin) (IHC (P))

Search
Proteintech
CXXC1 Polyclonal Antibody
{{$productOrderCtrl.translations['antibody.pdp.commerceCard.promotion.promotions']}}
{{$productOrderCtrl.translations['antibody.pdp.commerceCard.promotion.viewpromo']}}
{{$productOrderCtrl.translations['antibody.pdp.commerceCard.promotion.promocode']}}: {{promo.promoCode}} {{promo.promoTitle}} {{promo.promoDescription}}. {{$productOrderCtrl.translations['antibody.pdp.commerceCard.promotion.learnmore']}}
产品信息
27963-1-AP
种属反应
宿主/亚型
分类
类型
抗原
偶联物
形式
浓度
规格
纯化类型
保存液
内含物
保存条件
运输条件
产品详细信息
Immunogen sequence: MEGDGSDPE PPDAGEDSKS ENGENAPIYC ICRKPDINCF MIGCDNCNEW FHGDCIRITE KMAKAIREWY CRECREKDPK LEIRYRHKKS RERDGNERDS SEPRDEGGGR KRPVPDPDLQ RRAGSGTGVG AMLARGSASP HKSSPQPLVA TPSQHHQQQQ QQIKRSARMC GECEACRRTE DCGHCDFCRD MKKFGGPNKI RQKCRLRQCQ LRARESY (1-216 aa encoded by BC015733)
靶标信息
Proteins that contain a CXXC motif within their DNA-binding domain, such as CXXC1, recognize CpG sequences and regulate gene expression (Carlone and Skalnik, 2001).
仅用于科研。不用于诊断过程。未经明确授权不得转售。
篇参考文献 (0)
生物信息学
蛋白别名: CFP 1; CpG binding protein; CpG-binding protein; CXXC 1; CXXC finger 1; CXXC finger 1 (PHD domain); CXXC-type zinc finger protein 1; DNA-binding protein with PHD finger and CXXC domain; PCCX 1; PHD finger and CXXC domain-containing protein 1; PHF 18; SPP 1; unnamed protein product; ZCGPC 1; zinc finger, CpG binding-type containing 1
基因别名: 2410002I16Rik; 5830420C16Rik; CFP1; CGBP; CXXC1; hCGBP; HsT2645; PCCX1; PHF18; SPP1; ZCGPC1
UniProt ID: (Human) Q9P0U4
Entrez Gene ID: (Human) 30827